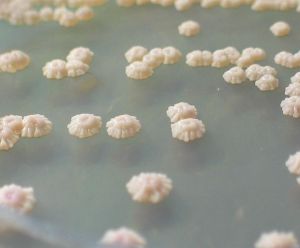
超級真菌 超級真菌

發現
超級真菌此後,韓國、巴基斯坦、印度、南非、肯亞、科威特、哥倫比亞、委內瑞拉和英國等至少12個國家報告發現了耳道假絲酵母菌感染病例。
2016年11月,美國疾病控制與預防中心(CDC)公布調查報告,表示首次在美國發現一種具抗藥性的致命超級真菌“耳道假絲酵母菌”,並有蔓延趨勢。
病例
CDC官員表示已確認7宗超級真菌感染個案,其中5宗在2016年發生,病人分別來自伊利諾伊、馬里蘭、新澤西及紐約州,他們全部出現嚴重病徵,確診後平均住院18日,當中4名病人死亡,但不清楚他們是否直接因真菌感染致死。
CDC在2016年8月之後發現其餘6宗感染個案,其中兩名來自新澤西州的病人在同一間醫院接受治療,他們身上的真菌菌株幾乎完全一樣,反映真菌可在醫療設施內傳播。此外,伊利諾州一名病人曾因其他疾病住院,研究人員在他使用的被子、桌椅等物品發現真菌蹤跡。
致病性
CDC指,在其他國家,有60%感染“耳道假絲酵母菌”的病人最終死亡,而大部分個案的真菌,均對3種主要藥物出現抗藥性,但美國未有發生這情況。